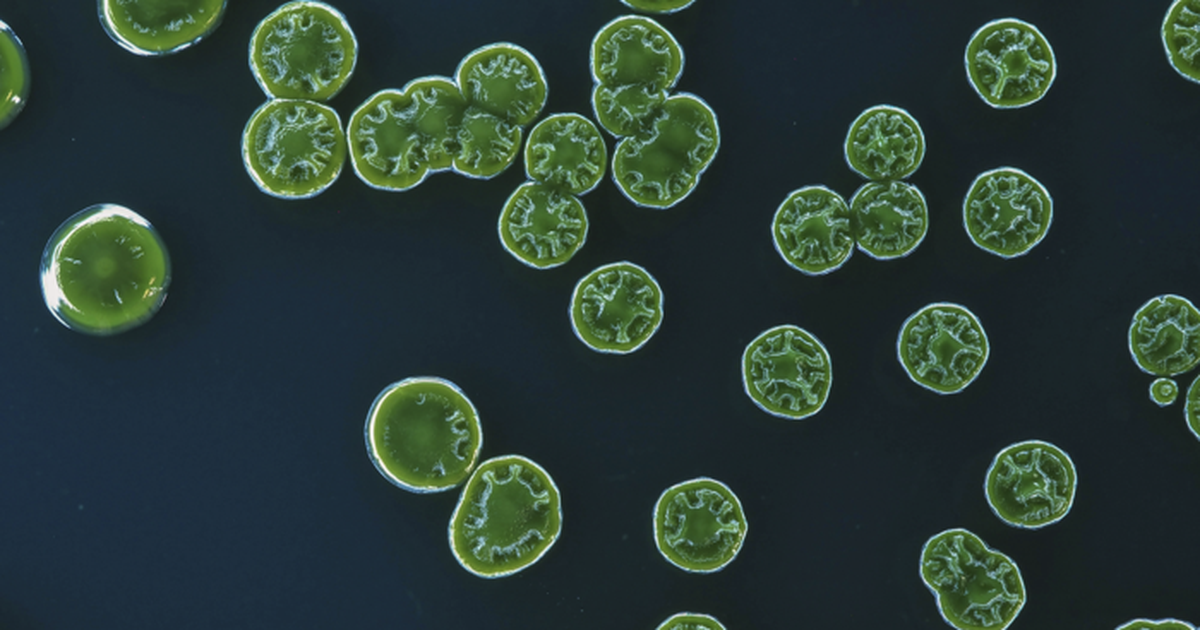

Recomiendan evitar cursos de agua por presencia de cianobacterias en la Laguna del Sauce
La presencia de cianobacterias fue detectada a fines de la semana pasada, el viernes, y desde entonces se trabaja en un ámbito interinstitucional.
La presencia de cianobacterias fue detectada a fines de la semana pasada, el viernes, y desde entonces se trabaja en un ámbito interinstitucional.